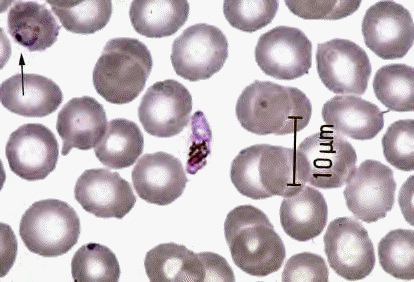

- "The gametocyte of
Falciparum malaria is easily recognizable by its
banana shape, making it a likely USMLE question.
An arrow in the upper left hand corner points to
a ring form, common in all types of malaria
(double rings usually mean Falciparum,
too)"-J. Fishback
- Ó
1999 James Fishback, KUMC Pathology and the
University of Kansas, used with permission;
courtesy of Dr. James Fishback, Department of
Pathology, University of Kansas Medical Center.
- return
to main menu
|